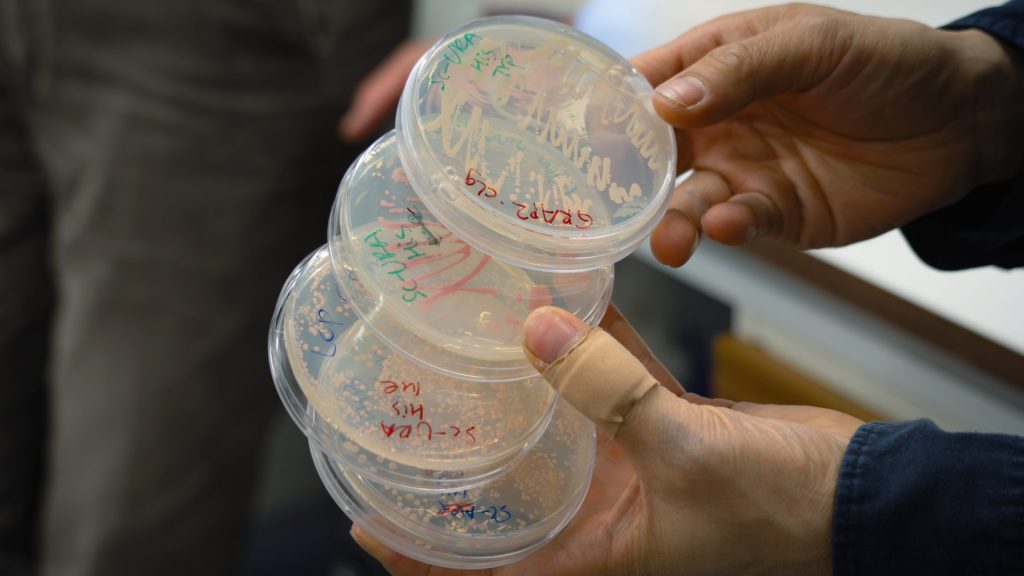

Vitt skilda typer av forskning pågår vid Umeå universitet för att bekämpa anorexi. Ett spår är att undersöka om brist på ett specifikt vitamin kan spela roll i sjukdomen. Ett annat är att studera jäst.
Olof Lagerlöf är biträdande lektor i psykiatri vid Institutionen för klinisk vetenskap samt ST-läkare vid Norrlands universitetssjukhus. I hans labb pågår forskning om anorexi.
I så kallade petriskålar odlas jäst, sådan som man kan använda till bakning. Kopplingen till anorexi kan verka långsökt, men syftet är att identifiera gener som kan vara intressanta att forska vidare på och jäst råkar vara ett effektivt försöksobjekt.
– Vi testar 8 000 olika gener. Det skulle bli väldigt opraktiskt att försöka göra det med möss, säger Olof Lagerlöf.
Självsvält, en lång historia
Självsvält i religiösa och andliga sammanhang finns dokumenterad sedan antiken. Under 1800-talet började man tala om ett sjukdomstillstånd som fick namnet anorexia nervosa. Idag finns tre huvudsakliga kriterier som ligger till grund för en diagnos: En skev kroppsbild där man upplever sig vara för fet, en strävan att begränsa vad man äter och hur mycket samt att man är extremt rädd för att äta mat som gör att man går upp i vikt.
– En person med anorexi känner ett behov av att kontrollera sig själv hela tiden, säger Magnus Sjögren, docent i psykiatri vid Institutionen för klinisk vetenskap.
Han är också verksamhetschef vid nationell högspecialiserad vård för allvarliga ätstörningar i Sundsvall och har träffat många patienter med svår anorexi.
– Framför allt kontrollerar de sitt födointag, men när de har ätit så finns också ett starkt behov av att bli av med det man ätit. Det kan vara antingen genom att träna för att förbränna kalorier eller genom att kräkas eller använda laxermedel. Och det här med att förbränna kalorier handlar inte om att motionera litegrann, utan det kan handla om flera timmar varje dag och även nattetid.
Om ätstörningar
Socialstyrelsen uppskattar att ungefär 200 000 personer i Sverige i åldern 15–60 år lider av någon form av ätstörning. Det är oklart hur många som lider av anorexi, men det är inte den vanligaste ätstörningen.
Några vanliga former av ätstörning är:
- Hetsätningssyndrom, som innebär episoder med hetsätningar
- Bulimi, som innebär episoder med hetsätning följt av kompensatoriska beteenden som kräkning
- Ospecificerad ätstörning, som kan vara blandformer av de andra tillstånden.
Ungefär 80 procent av dem som drabbas av ätstörningar är kvinnor. Det är vanligt att växla mellan olika typer av ätstörningar. Det finns också ofta annan problematik jämte ätstörningen, som depression, ångest, självskadebeteende eller tvångssyndrom.
Källa: Umeå universitet
Kan triggas av annat
– Ätstörningar kan vara en egen åkomma, men det är också möjligt att en ätstörning kan triggas av en annan sjukdom, säger Peter Asellus, lektor i psykiatri vid Institutionen för klinisk vetenskap samt överläkare vid Norrlands universitetssjukhus.
– Vid en depression är det till exempel vanligt att man har en väldigt negativ självbild och att man får sämre aptit. Och något som då kan göra att man kanske mår lite bättre är att man låter bli att äta, nästan som ett straff. Det här är beteenden som man sedan kan tappa kontrollen över.
Ätstörningen styr
Ju mer intensiv sjukdomen är, desto mer påverkar den livet. På kort sikt kan man uppleva en belöning när man klarar de krav som sjukdomen ställer på en, men det håller sällan över tid. Magnus Sjögren beskriver det som att sjukdomen till slut tar över patienternas liv och att de styrs av ätstörningen. De beteenden som upprätthåller sjukdomen blir också till vanor, vilket gör att det generellt sett är svårare att bli frisk om man varit sjuk länge.
– Jag sticker ut hakan ibland och kallar detta för ett beroendetillstånd. Precis som vid rökning eller missbruk finns delar i ätstörningen som liknar ett beroendesyndrom. De här personerna återvänder till sjukdomen eftersom den är en trygghet, säger Magnus Sjögren.
Energi behövs
Anorexi är den psykiatriska diagnos som har högst dödlighet, någonstans mellan fem och tio procent. Den grymma ironin i sjukdomen är att en viktig faktor för effektiv behandling är att man går upp i vikt.
– Man kan se att den som går ner i vikt till en skadlig nivå blir mer rigid i sitt tankesätt, oavsett om man har anorexi eller inte. Den låga kroppsvikten gör det svårt att ta till sig information, och att gå igenom KBT för sin anorexi kräver mycket av dig. Du måste ha energi nog att lyssna på terapeuten, säger Olof Lagerlöf.
Fokusera på mående
Samtidigt är det viktigt att poängtera att många som drabbas av anorexi blir friska eller åtminstone mår bättre efter behandling. Majoriteten går med på att göra vissa åtgärder, till exempel en kostplan eller en psykologisk behandling. Peter Asellus menar också att om man behandlar den samsjuklighet som finns hos många personer med anorexi kan det påverka vikten positivt, även om det inte är huvudfokus.
– Det viktigaste är att få patienterna att må bättre. Någonstans är det ju kopplat till att man inte är nöjd som det är nu, och ett sätt att förändra det är att gå ner i vikt – man tänker att då blir saker bättre. Men om man i stället först kan få saker att bli bättre så är det kanske inte lika viktigt att gå ner i vikt längre. Om det leder till att du går upp i vikt senare är det för att du känner dig bekväm med det.
Hjärnan funkar annorlunda
Det är känt att miljöfaktorer och sociala faktorer spelar roll när någon utvecklar anorexi. Men det är inte hela sanningen. Genetiska studier har identifierat genprofiler som bidrar och det finns en ärftlighet som kan vara upp till 60 procent. Forskning har också visat att hjärnan hos personer med anorexi reagerar annorlunda än hos andra.
– En koppling i hjärnan som har visat sig fallera hos personer med anorexi är kopplingen mellan ångestområden och ämnesomsättningsområden. Hjärnan verkar feltolka kroppens biologiska signaler så att den reagerar med ångest när man får i sig kalorier. Hjärnan tror helt enkelt att man utsätts för något hemskt, säger Olof Lagerlöf.
Även möss kan svälta sig
Samma mekanism kan ses hos djur. I Olof Lagerlöfs labb har forskare visat att möss som under en period får begränsat med mat, samtidigt som de har tillgång till ett springhjul, kan hamna i ett tillstånd som liknar anorexi. Mössen visar samma beteenden med självinducerad svält och överdriven fysisk aktivitet.
– Om man bara begränsar matintaget för mössen brukar kroppsvikten vara ganska stabil. Men av någon anledning är det så att om de också har tillgång till ett springhjul så äter vissa möss ännu mindre och gör av med mycket mer energi. De verkar välja att springa i stället för att äta. Man tycker att biologin borde rädda dig, men här är det tvärtom så att biologin verkar försvåra för dig. Och de som är i den största riskzonen för att hamna i det här beteendet är honmöss i tonåren.
Vitamin kan spela roll
Olof Lagerlöf och Peter Asellus menar att det finns för lite forskning om de biologiska aspekterna av anorexi. Peter Asellus forskar bland annat på betydelsen av tiamin, en typ av B-vitamin, och vilken roll tiaminbrist spelar vid anorexi. Tiamin är nödvändigt när hjärnan använder sitt huvudsakliga bränsle, glukos. Om den processen startar utan att det finns tillräckligt med tiamin kan det leda till hjärnskador. Det skulle kunna göra att det finns en skyddande effekt i att inte äta, så att hjärnan inte har tillgång till glukos.
Kanske kan brist på hungerskänslor ibland vara en typ av skyddsmekanism, säger Peter Asellus.
– Och kan man då kickstarta aptiten genom att ge tillskott av tiamin? Det är ju svårt att behandla en ätstörning om man inte ens har någon aptit, men genom att tillföra tiamin skickar man en signal till kroppen att det är lugnt att äta.
Studera hjärnan i detalj
I labbet bor jästcellerna granne med högteknologisk utrustning för miljontals kronor. Med den studerar man bland annat hur man med stor precision kan avbilda specifika områden i hjärnan. Olof Lagerlöf tror att psykiatrins framtid, både för ätstörningar och för andra sjukdomar, är att kunna gå in i de enskilda neuronala kretsar som hjärnans olika delar kommunicerar genom.
Läkemedel slår mot hela hjärnan och det är svårt att hitta specifika mål. Det är bland annat därför som läkemedelsanvändare kan få många biverkningar.
– Men kan vi hitta kopplingen mellan nervcell ett och två, att det är den vi ska slå emot… Sådan behandling finns idag för vissa neurodegenerativa tillstånd, att man till exempel går in med ett visst virus, men inte inom psykiatrin. Principen är där men det är en behandlingsstrategi som kanske ligger tio, femton, tjugo år bort, säger Olof Lagerlöf.
Detta är en bearbetning av en artikel som först publicerades på Umeå universitets webbplats: Möss, människor och molekyler – anorexiforskning i framkant.



